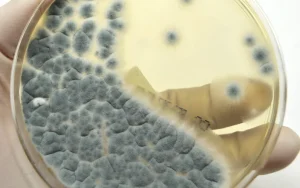

Aspergilloz Nedir?
Aspergilloz, Aspergillus türüne ait mantarların neden olduğu enfeksiyonların genel adıdır. Aspergillus, doğada yaygın olarak bulunan, genellikle toprakta, çürüyen organik maddelerde ve özellikle nemli ortamda üreyen bir mantar cinsidir. İnsanlar bu mantarın sporları ile enfekte olabilirler, ancak enfeksiyon riski genellikle bağışıklık sistemi zayıf olan bireylerde daha yüksektir. Aspergilloz, genellikle akciğerleri etkileyen bir enfeksiyon olsa da, diğer organlara da sıçrayabilir ve farklı klinik tablolara yol açabilir.
Aspergilloz, üç ana türde ortaya çıkabilir:
- Akut Aspergilloz: Bu tür enfeksiyon genellikle bağışıklık sistemi baskılanmış veya zayıf olan bireylerde gelişir ve hızla ilerleyebilir. Enfeksiyonlar, akciğerlerde ciddi hasara yol açabilir.
- Kronik Aspergilloz: Daha yavaş ilerleyen bir türdür ve genellikle daha uzun süre devam eder. Bu enfeksiyon, bağışıklık sistemi zayıf olmayan bireylerde bile görülebilir.
- Allerjik Aspergilloz: Bu form, alerjik reaksiyonlara yol açan aspergillus mantarının neden olduğu hastalıklardır. Astım veya kronik bronşit gibi hastalıkları olan kişilerde daha yaygındır.
Aspergillozun Nedenleri ve Risk Faktörleri
Aspergillus mantarları doğada yaygın olarak bulunur ve bu mantarların sporları hava yoluyla yayılabilir. Aspergillozun gelişmesi için, bu sporların vücuda girmesi gerekmektedir. İnsanlar, özellikle solunum yoluyla bu sporlarla enfekte olabilirler. Birçok insan, Aspergillus sporlarına maruz kalmasına rağmen enfeksiyon geliştirmez, çünkü sağlıklı bir bağışıklık sistemi bu tür enfeksiyonları engelleyebilir. Ancak, bağışıklık sistemi zayıf olan bireylerde Aspergilloz riski önemli ölçüde artar.
Aşağıda, aspergillozun gelişmesine neden olan başlıca risk faktörleri bulunmaktadır:
1. Bağışıklık Sistemi Zayıflığı
Bağışıklık sistemi zayıf olan bireyler, aspergilloz gibi enfeksiyonlara daha yatkındır. Kemoterapi gören kanser hastaları, organ nakli yapılan bireyler, HIV/AIDS gibi bağışıklık sistemini zayıflatan hastalıkları olan kişiler, aspergilloz riskinin yüksek olduğu gruplardır.
2. Solunum Yolu Hastalıkları
Astım, bronşit, KOAH (Kronik Obstrüktif Akciğer Hastalığı) gibi solunum yolu hastalıkları, aspergilloz gelişme riskini artırabilir. Bu hastalıklar, solunum yollarının zaten zayıf ve hasar görmüş olmasına neden olur, bu da mantarların daha kolay enfeksiyon oluşturmasına zemin hazırlar.
3. Uzun Süreli Steroid Kullanımı
Bağışıklık sistemini baskılayan ilaçların uzun süre kullanımı, aspergilloz riskini artırabilir. Özellikle steroidler, bağışıklık sistemini zayıflatarak Aspergillus mantarlarının çoğalmasına yol açabilir.
4. Alerjik Duyarlılık
Bazı bireylerde aspergillus mantarına karşı alerjik bir duyarlılık gelişebilir. Alerjik aspergilloz, mantarın vücutta alerjik reaksiyonlara yol açması sonucu gelişir. Bu durum, genellikle solunum sistemi üzerinde etkili olur ve astım gibi hastalıkları tetikleyebilir.
5. Akciğer Hastalıkları ve Sigara İçme
Sigara içiciliği, akciğer hastalıkları ve özellikle sigara dumanına maruz kalmak, aspergillus sporlarının vücuda girmesini kolaylaştırabilir. Bu, solunum yollarında enfeksiyonların oluşma olasılığını artırır.
6. Kontrollü Ortamlarda Maruziyet
Aspergillus mantarlarının sporları, özellikle iç mekanlarda (örneğin, yapıların çürüyen bölgelerinde, nemli ortamlarda) yoğun olabilir. Bu gibi ortamlarda, uzun süre kalan kişiler, mantar sporlarına maruz kalma riski taşır.
Aspergillozun Belirtileri
Aspergilloz, vücudun hangi bölgesini etkilediğine göre değişen farklı belirtilerle kendini gösterebilir. Akciğerlerde görülen aspergilloz, genellikle en yaygın formdur, ancak mantar enfeksiyonları diğer organlara da yayılabilir. Aspergillozun belirtileri şunları içerebilir:

1. Solunum Sorunları
Akciğerlerde görülen aspergilloz, öksürük, nefes darlığı, göğüs ağrısı ve balgam üretimi gibi belirtilerle başlar. Bu belirtiler, enfeksiyonun şiddetine bağlı olarak artabilir.
2. Ateş ve Halsizlik
Ateş, vücudun enfeksiyona karşı verdiği bir yanıttır ve aspergillozun yaygın bir belirtisidir. Ayrıca halsizlik, yorgunluk ve iştah kaybı gibi genel rahatsızlık hissi de sıkça görülür.
3. Kanlı Balgam
İleri aşamalarda, aspergilloz akciğerlerde kanamaya yol açabilir. Bu durumda, hastalar kanlı balgam çıkarmaya başlayabilir.
4. Alerjik Reaksiyonlar
Allerjik aspergilloz, özellikle astım hastalarında daha yaygındır. Bu formda, burun tıkanıklığı, hapşırık, gözlerde kaşıntı ve sulanma gibi alerjik belirtiler görülebilir.
5. Diğer Organlara Yayılım
Nadir durumlarda, aspergilloz, akciğerlerden diğer organlara (örneğin, sinir sistemi, böbrekler veya karaciğer) yayılabilir. Bu durum ciddi komplikasyonlara yol açabilir.
Aspergillozun Tanısı
Aspergillozun tanısı, genellikle klinik belirtiler ve çeşitli laboratuvar testleri ile konur. Tanı koyarken kullanılan başlıca yöntemler şunlardır:

- Radyolojik Testler Göğüs röntgeni veya bilgisayarlı tomografi (BT) taramaları, akciğerlerdeki mantar enfeksiyonlarının tespiti için kullanılır. BT taraması, aspergillozun akciğerlerde oluşturduğu hasarı daha net bir şekilde gösterebilir.
- Kan Testleri Aspergillus enfeksiyonunun teşhisinde, spesifik antikor ve antijen testleri yapılabilir. Bu testler, vücudun mantara karşı geliştirdiği bağışıklık yanıtını ölçer.
- Balgam Kültürü Balgam örneği alınarak, aspergillus mantarının varlığı tespit edilebilir. Balgam kültürü, mantarın türünü belirlemeye yardımcı olur.
- Doku Biyopsisi Eğer enfeksiyon vücudun başka organlarına yayılmışsa, biyopsi yapılabilir. Biyopsi, mantarın bulunduğu dokudan alınan örnekle teşhis koymayı sağlar.
- Bronkoskopi Bronkoskopi, akciğerlerdeki enfeksiyonları incelemek için yapılan bir prosedürdür. Bu işlem, doktorların akciğerlerdeki mantar enfeksiyonlarını doğrudan gözlemlemelerini sağlar.
Aspergillozun Tedavisi
Aspergilloz tedavisi, enfeksiyonun türüne, şiddetine ve hastanın genel sağlık durumuna bağlı olarak değişir. Tedavi yöntemleri şunları içerebilir:
1. Antifungal İlaçlar
Aspergilloz tedavisinde, antifungal ilaçlar kullanılır. Bunlar, mantar enfeksiyonunun yayılmasını engellemek amacıyla reçete edilir. En yaygın antifungal ilaçlar arasında amfoterisin B, itrakonazol, vorikonazol ve posakonazol yer alır.
2. Cerrahi Müdahale
Bazı durumlarda, aspergilloz nedeniyle akciğerlerde büyük hasar oluşabilir. Bu durumda, enfekte olmuş dokunun cerrahi olarak çıkarılması gerekebilir.
3. Bağışıklık Sistemi Destekleyici Tedavi
Bağışıklık sistemi baskılanmış hastalar için bağışıklık sistemini güçlendirici tedaviler gerekebilir. Kemoterapi gören veya organ nakli yapılan hastalar için bağışıklık sistemi destekleyici tedavi önemli olabilir.
4. Destekleyici Tedavi
Ayrıca, aspergilloz tedavisinde destekleyici tedavi de kullanılabilir. Bu tedavi, hastanın bağışıklık sistemini güçlendirmeye ve enfeksiyonlarla mücadele etmeye yardımcı olur.
Aspergilloz, aspergillus mantarlarının neden olduğu ve ciddi sağlık sorunlarına yol açabilen bir enfeksiyon hastalığıdır. Özellikle bağışıklık sistemi zayıf olan bireyler için büyük bir risk oluşturur. Erken tanı ve uygun tedavi, enfeksiyonun yayılmasını ve ciddi komplikasyonları önlemek için büyük önem taşır. Tedavi genellikle antifungal ilaçlar, cerrahi müdahaleler ve bağışıklık sistemi destekleyici tedaviler içerir.
